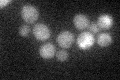
YLR082C
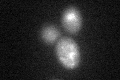
YLR082C
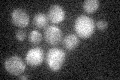
YLR082C

View description
Protein of unknown function; overexpression suppresses the lethality caused by a rad53 null mutation
Localization:
Intensity:
Fold change:
Significance:
-
C’ GFP library in SD
below threshold16.04 -
N' NOP1pr-GFP in SD

nucleus61.9851 -
N' TEF2pr-mCherry in SD

nucleus7.0483 -
N' NATIVEpr-GFP in SD

punctate,nucleus17.2177 -
N' TEF2pr-VC and Cyto-VN in SD

nucleus32.0624 -
C’ GFP library in SD+DTT
cytosol15.330.95No -
C’ GFP library in SD+H2O2
cytosol18.011.12No -
C’ GFP library in Starvation Media

cytosol26.141.62No -
C’ GFP library on the background of Pup2-DaMP

below threshold -
C’ GFP library on the background of CCT mutant

below threshold16.53491.03004No
